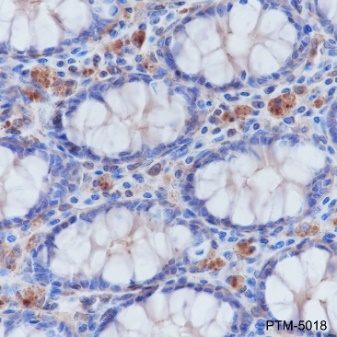

Background
Actin is a highly conserved protein that polymerizes to produce filaments that form cross-linked networks in the cytoplasm of cells. Actin exists in both monomeric (G-actin) and polymeric (F-actin) forms, both forms playing key functions, such as cell motility and contraction. In addition to their role in the cytoplasmic cytoskeleton, G- and F-actin also localize in the nucleus, and regulate gene transcription and motility and repair of damaged DNA.
Cellular location
Cytoskeleton, Cytoplasm